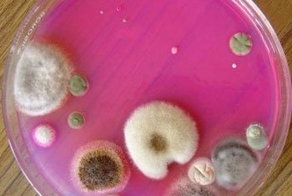

33501
27
Предлагаю подборку познавательных и интересных фактов про человека, из жизни, животных , науку и историю.
Предыдущая часть
Предыдущая часть
×
Источник:
Ссылки по теме:
- Разноцветные Факты
- А вы знали, что...
- 11 фактов, которые должны быть общеизвестными
- А вы знали, что...
- А вы знали, что...

Согласно молекулярно-генетическим данным и китообразные, и парнокопытные относятся к кладе китопарнокопытные, в которую входят киты, бегемоты и все парнокопытные. Более того, по этим данным бегемоты являются одними из ближайших живых родственников китов; они произошли от общего предка, жившего примерно 54 миллиона лет назад.